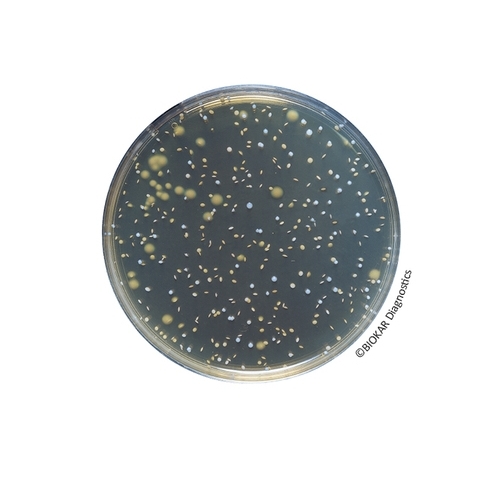
MRS Agar

MRS Agar
MRS Agar is used for the growth and enumeration of cultures of Lactobacillus in dairy and other food products as well as in products destined for animal feed. The medium can be used to culture slowly-growing lactobacilli such as Lactobacillus brevis and Lactobacillus fermentum. Acidified to low pH, it can be used to enumerate Lactobacillus bulgaricus in yogurts. According to the bacteria sought, the media can be adjusted in pH to obtain optimal growth.